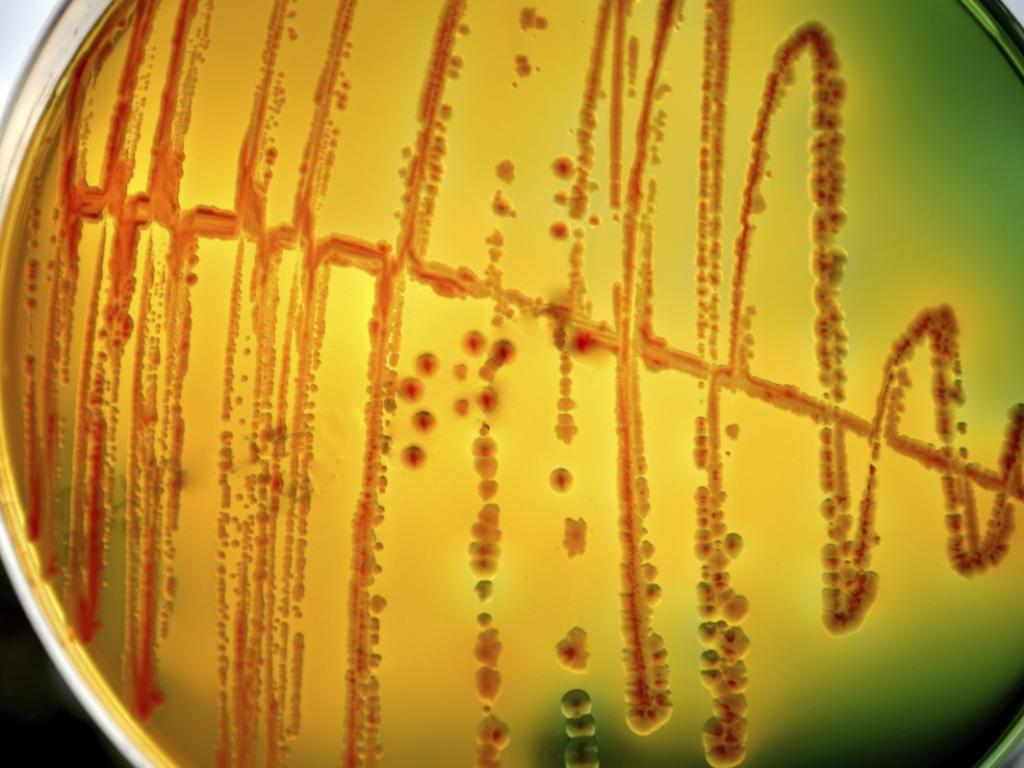
Ястие от мечешко месо на скара се оказало отровно след

... адекватното готвене е единственият надежден начин за унищожаване на паразитите Trichinella“, се казва в доклада. * Видеото е илюстративно: Не пропускайте най-важните новини - последвайте ни в
Кебап Месо - Новини
Райлън Кларк моделира смокинг с месо който споменава кебап за
...... приложение". Гласуването приключва на 21 януари, а победителите са обявени на 15 февруари. * Следете Mirror Celebs в Snapchat, Instagram, Twitter, Facebook, YouTube и Threads.
Когато сме в настроение за месце ни се хапва точно
...... 30 минути. Изважда се и поръсва с настърган кашкавал. Запича се до златисто за още 10-15 минути. Султан кебапът с телешко месо е много вкусен.
И да споделите мнение за това ястиеНеобходими Продукти● кисело зеле
...... сервиране всяка порция кебап се залива с чесновата смес на вкус и се разбърква. Пазарджишкият тепси кебап с пуешко месо и кисело зеле е готов.
Класика в кухнята изпитана рецепта за кебап със свинско
...... като периодично разбъркваме, докато месото и лукът омекнат и останат на мазнина. Кебапа поднасяме, поръсен с нарязан пресен магданоз. Кебапът със свинско месо е готов.
Най накрая ни изпратиха и хубава рецепта за винен
...... омекне. В отделен съд сваряваме ориза с 3 ч.ч. подсолена вода. Кебапът ни е готов за сервиране! Виненият кебап с телешко месо е много вкусен.
На трапезата винаги ще има място за класическия винен кебап
...... на месото, ако е необходимо долейте гореща вода. Класическият винен кебап със свинско месо се поднася топъл, с гарнитура от варен ориз или картофено пюре.
Друсан кебап от свинско месо всички обичатНеобходими Продукти● свинско месо
...... червен пипер. И накрая подрусах още малко до пълното омекване на продуктите. И готово... Имаме друсан кебап от свинско месо, който сервираме с любима салата.
Да ви е сладко с този книжен кебап със свинско
...... с ръка. Готовите порции кебап се нареждат в тавичка. Налива се малко вода и книжния кебап със свинско месо се пече на 200°C около час.
Внимание Опасно вкусен кебап Опитате ли веднъж няма спиране Да
...... Връща се във фурната, пече се докато се зачерви. Пече се за около 30-40 минути. Кебапът със свинско месо в кори за баница е готов.
Ще ви гостим с кебап от свинско месо по секуловски
...... Може да се сервира с домашна туршия, свежа салата, с картофено пюре - въпрос на вкус. Кебапът от свинско месо по секуловски е уникален, опитайте.
Класическо ястие което има своите заклети почитатели в наше лицеНеобходими
...... като го свалим от огъня поръсваме със ситно нарязан магданоз (по желание). Гарнитура за винения кебап с крехко месо е картофено пюре, може и ориз.
Вкусотии за цялото семейство Сочен Адана кебап с мляно
...... наредете адана кебапа, предварително намазан обилно с олио. Печете от двете страни до готовност. Сервирайте скарата с гарнитура по ваш вкус. Да ви е вкусно!
Вкусно по вкусно най вкусният кебап от свинско месо в тестоНеобходими Продукти●
...... кебап, увиваме и увиваме в кръг като вита баница. Или по друг предпочитан от вас начин. Печем на 200 градуса до готовност. Около 20-25 минути.
Свежи идеш за вашата трапеза ефектен кебап който заслужава
...... първоначалното възприятие у детето. Да се постараем още от най-ранна детска възраст да възпитаме у него вкус към храната, която да бъде разнообразна и здравословна.
Така е и с обикновено свинско ще стане вкусно но
...... него. Поръсете със сол на вкус. Оставете да къкри, докато месото започне да се отделя само с докосване на вилицата. Невероятно вкусно и ароматно ястие.
С хубаво вино хубав кебап става са казали майсторите И
...... подправки и гозбата се оставя на огъня, докато се сготви напълно. Свинският кебап се поднася към сварен ориз, смесен с масло. Аранжира се с магданоз.
Изпитана рецепта за любимия на всички свински кебап поднесен
...... купичка слагаме от месото, покриваме с ориз и притискаме добре. Обръщаме купичката в чиния и поливаме със соса от месото. Поръсваме с нарязан пресен магданоз.
Мъжки кебап който има нужда от силно домашно червено вино
...... минута. Добавят се едро нарязания лук и виното. Чушките се препичат и се слагат заедно с подправките. Посолява се. На слаб огън ври 30 мин.
Екзотичен кебап с два вида месо какъвто не сте опитвали
...... кюфтенца, които се приплескват и се нанизват на шишове. Разполовете доматите и ги нанижете на отделни шишове. Запечете на загрят грил, предварително намазан с масло.
Само ако знаете колко е вкусно вече да сте пуснали
...... месо на шиш за около 12 минути от едната страна и обърнете. Поднесете със нарязаните домати, лук и царевица, овкусени със зехтин, лайм и кориандър.
Странна работа само като чуем кебап и огладнявамеНеобходими Продукти● пуешко
...... дребно домат и около 1 ч.ч. гореща вода. Оставете ястието да къкри, докато остане почти изцяло на мазнина. Поднесете с гарнитура от ориз по желание.
Между романтична почивка и порция агнешки кебап 80 от
...... до готовност на слаб огън. Изсипете го в тава, полейте със заливка от разбитите яйца с прясното мляко и запечете Касапския гювеч на силна фурна.
Усещате ли аромата на крехко телешко месо в богат сос Необходими
...... 4 пръста над продуктите. Вари се на силен огън за 10 минути, след което на умерен, за още 40 минути. Сервира се с подходяща гарнитура.
Тази рецепта е рожба на в която да оползотвори
...... преди да е готов напълно и все още има вода го изключвам и не вдигам капака. Тогава става точно по начина, по който ми харесва.
Предлагаме ви традиционна рецепта за винен кебап със свинско месо
...... сервира заедно с ориза като той се поставя в единия край на чинията. Поръсете ястието със ситно накълцан магданоз. Добър апетит! Още от РЕЦЕПТИ:
Зимата и особено по Коледа свинското месо е задължително Без
...... истински зимно ястие, което се приготвя лесно и бързо и е подходящо и за най-начинаещите готвачи. Необходими продукти: 1 кг свинско месо 2 стръка праз
Птица и кебап от свинското месо присъстват на трапезата в
...... Бъдни вечер, а залците от питата могат да се сложат под възглавницата с това наричане, че когото сънуваш, за него ще се ожениш.Източник: ИА Фокус